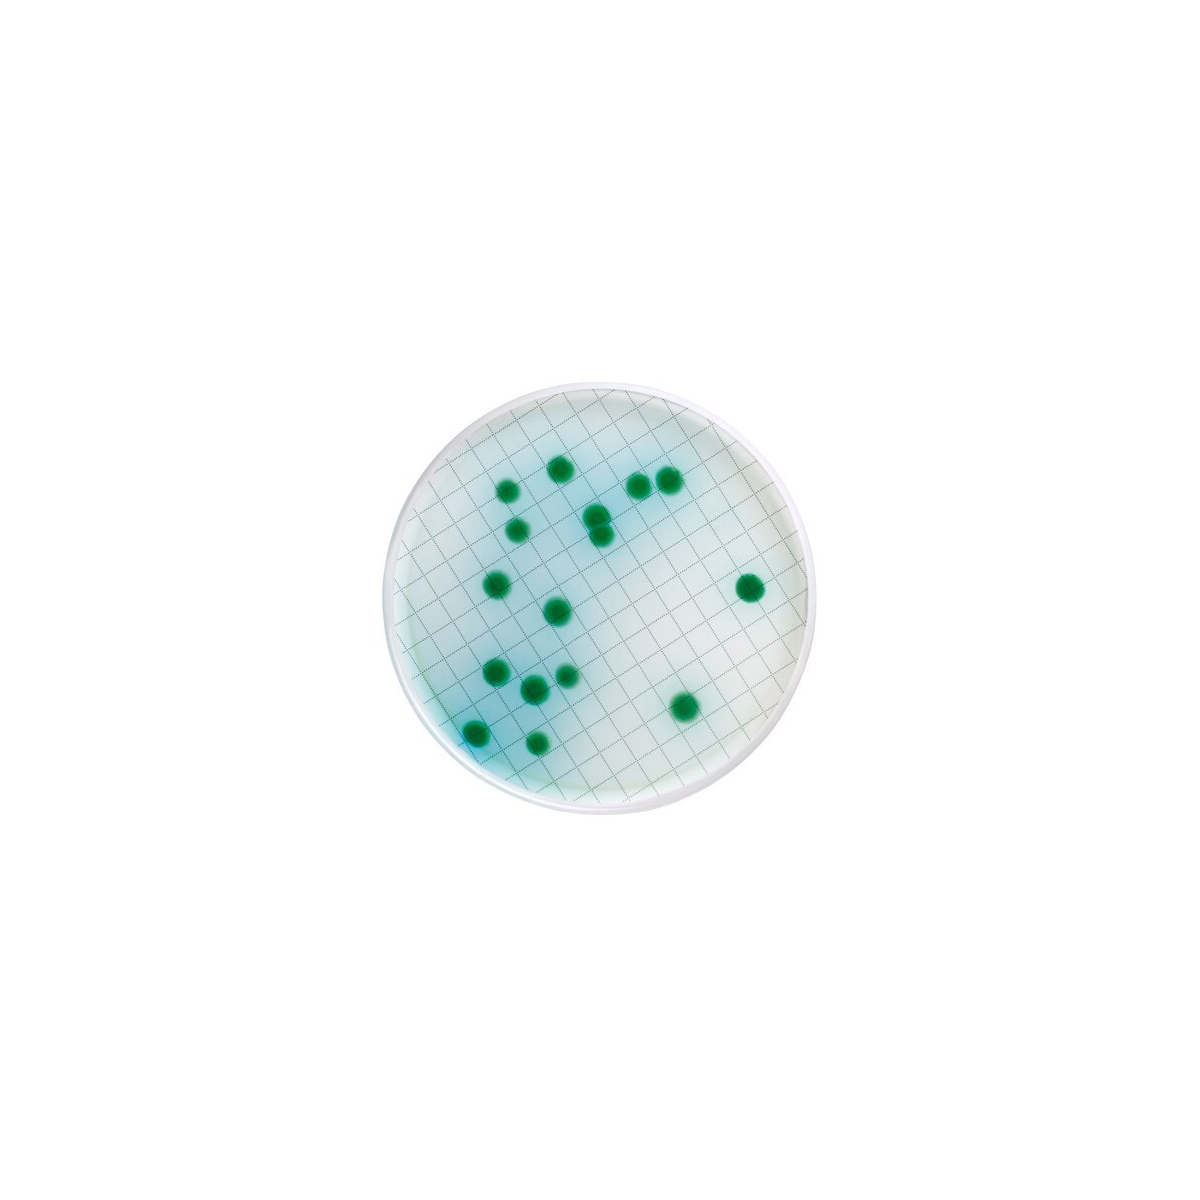

1
/
/
1
SKU-koodi:MXSMCET48
Merck
Milliflex Cetrimide agar
Milliflex Cetrimide agar
Ei varastossa
Tuotteen kuvaus
Tuotteen kuvaus
Cetrimide Agar, Naladixic Acid, for Pseudomonas aeruginosa, pack of 48 tests, suitable for bioburden testing
Lisätietoja
Lisätietoja
Lataukset / käyttöohjeet
Lataukset / käyttöohjeet